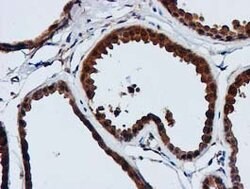
GATM Mouse anti-Human, Clone: OTI1E3, lyophilized, TrueMAB 100 &mu;g; Unconjugated:Antibodies,

Learn More
GATM Mouse anti-Human, Clone: OTI1E3, lyophilized, TrueMAB™
Mouse Monoclonal Antibody
Brand: Origene Technologies CF503207

Description
Reconstitute with PBS (pH 7.3) and recommend to perform another round of desalting process using Product No. 7KMWCO
AGAT, also known as glycine amidinotransferase (L-arginine:glycine amidinotransferase), GATM or transamidinase, is a 423 amino acid protein belonging to the amidinotransferase family. Encoded by a gene that maps to human chromosome 15q21.1, AGAT exists as three alternatively spliced isoforms and consists of a homodimer, with equilibrium between monomeric and dimeric forms favoring a monomer subunit structure. AGAT localizes to mitochondrial inner membranes, peripheral membranes and cytoplasm. Biallelically expressed in placenta and fetal tissues, AGAT is also expressed in brain, heart, liver, lung, salivary gland and skeletal muscle tissue, with high expression in kidney. AGAT is elevated in the myocardium during heart failure and is decreased in inter-uterine growth restriction (IUGR)-associated placenta. AGAT catalyzes biosynthesis of guanidinoacetate, the immediate precursor of creatine, which plays a vital role in energy metabolism in muscle tissues. AGAT defects are associated with arginine:glycine amidinotransferase deficiency, an autosomal recessive disorder characterized by developmental delay or regression, mental retardation, severe disturbance of expressive and cognitive speech and severe depletion of creatine/phosphocreatine in brain. AGAT may be linked to embryonic and central nervous system development and may function in heart failure response by elevating local creatine synthesis.Specifications
| GATM | |
| Monoclonal | |
| Unconjugated | |
| GATM | |
| AGAT, AT, CCDS3 | |
| Mouse | |
| Affinity Chromatography | |
| RUO | |
| 2628 | |
| -20° C, Avoid Freeze/Thaw Cycles | |
| Lyophilized |
| Flow Cytometry, Immunocytochemistry, Immunofluorescence, Immunohistochemistry (Paraffin), Western Blot | |
| OTI1E3 | |
| PBS with 8% trehalose and no preservative; pH 7.3 | |
| P50440 | |
| GATM | |
| Full length human recombit protein of human GATM produced in HEK293T cell. | |
| 100 μg | |
| Primary | |
| Human | |
| Antibody | |
| IgG2a |
The Fisher Scientific Encompass Program offers items which are not part of our distribution portfolio. These products typically do not have pictures or detailed descriptions. However, we are committed to improving your shopping experience. Please use the form below to provide feedback related to the content on this product.